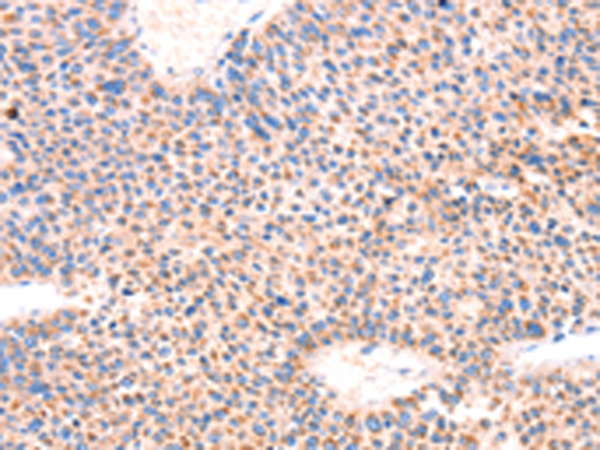
一抗

中文名稱: 兔抗AMPD1多克隆抗體
英文名稱: Anti-AMPD1 rabbit polyclonal antibody
別 名: MAD; MADA
相關(guān)類別: 一抗
儲 存: 冷凍(-20℃)
宿 主: Rabbit
抗 原: AMPD1
反應(yīng)種屬: Human
標(biāo) 記 物: Unconjugate
克隆類型: rabbit polyclonal
技術(shù)規(guī)格
|
Background: |
Adenosine monophosphate deaminase 1 catalyzes the deamination of AMP to IMP in skeletal muscle and plays an important role in the purine nucleotide cycle. Two other genes have been identified, AMPD2 and AMPD3, for the liver- and erythocyte-specific isoforms, respectively. Deficiency of the muscle-specific enzyme is apparently a common cause of exercise-induced myopathy and probably the most common cause of metabolic myopathy in the human. Alternatively spliced transcript variants encoding different isoforms have been identified in this gene. |
|
Applications: |
ELISA, WB, IHC |
|
Name of antibody: |
AMPD1 |
|
Immunogen: |
Synthetic peptide of human AMPD1 |
|
Full name: |
adenosine monophosphate deaminase 1 |
|
Synonyms: |
MAD; MADA |
|
SwissProt: |
P23109 |
|
ELISA Recommended dilution: |
2000-10000 |
|
IHC positive control: |
Human liver cancer and Human thyroid cancer |
|
IHC Recommend dilution: |
100-300 |
|
WB Predicted band size: |
90 kDa |
|
WB Positive control: |
Human fetal muscle tissue |
|
WB Recommended dilution: |
500-2000 |


 購物車
購物車 幫助
幫助
 021-54845833/15800441009
021-54845833/15800441009